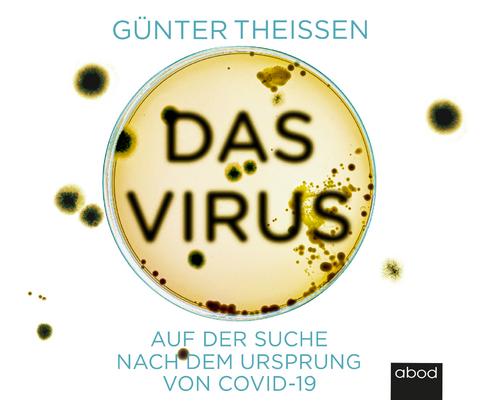
Das Virus - G&uuml;nter Theissen

Das Virus
Auf der Suche nach dem Ursprung von Covid-19
Seiten
2022
ABOD Verlag
978-3-95471-900-6 (ISBN)
ABOD Verlag
978-3-95471-900-6 (ISBN)
- Titel ist leider vergriffen;
keine Neuauflage - Artikel merken
Woher kommt Corona?SARSCoV2 hält seit über zwei Jahren die Welt in Atem. Doch wo liegt der Ursprung des Virus und wie genau ist es entstanden? Wie ein Krimi nal kommissar hat sich der erfahrene Molekularbiologe Günter Theißen auf Spurensuche begeben und seit Anbeginn der Pandemie alle verfügbaren Fakten zusammenge tragen. Schon bald musste er jedoch feststellen, dass sich die Mehrzahl der Fachleute und ein Großteil der Medien auf eine rein natürliche Entstehung des Virus festgelegt haben - ohne hieb und stichfeste Beweise! Warum besteht so wenig Interesse daran, die Wahrheit zu erfahren?Zusammen mit gleichgesinnten Kollegen setzt sich Theißen für eine vorurteilsfreie Aufklärung der Entstehung des Virus und eine unabhängige Wissenschaft ein. Die Widerstände, die sich dieser kritischen Suche in den Weg stellen,offenbaren die akuten Schwachstellen unserer Wissenschaftskultur, der Medienlandschaft und der internationalen Politik.
| Erscheinungsdatum | 07.06.2022 |
|---|---|
| Mitarbeit |
Sprecher: Klaus B.Wolf |
| Verlagsort | DE |
| Sprache | deutsch |
| Maße | 124 x 142 mm |
| Gewicht | 193 g |
| Themenwelt | Sachbuch/Ratgeber ► Geschichte / Politik ► Politik / Gesellschaft |
| Sachbuch/Ratgeber ► Gesundheit / Leben / Psychologie | |
| Schlagworte | Corona • Forschung • Ursprung • Virus |
| ISBN-10 | 3-95471-900-2 / 3954719002 |
| ISBN-13 | 978-3-95471-900-6 / 9783954719006 |
| Zustand | Neuware |
| Informationen gemäß Produktsicherheitsverordnung (GPSR) | |
| Haben Sie eine Frage zum Produkt? |
Mehr entdecken
aus dem Bereich
aus dem Bereich
Eine Reise von der Mitte der Gesellschaft bis an die Ränder der …
Audio Disc (2025)
Lübbe Audio (Verlag)
CHF 30,80
Audio Disc (2025)
Der Audio Verlag
CHF 33,55
Wahr, falsch, plausibel | Die größten Streitfragen wissenschaftlich …
Audio Disc (2025)
Argon (Verlag)
CHF 13,95


